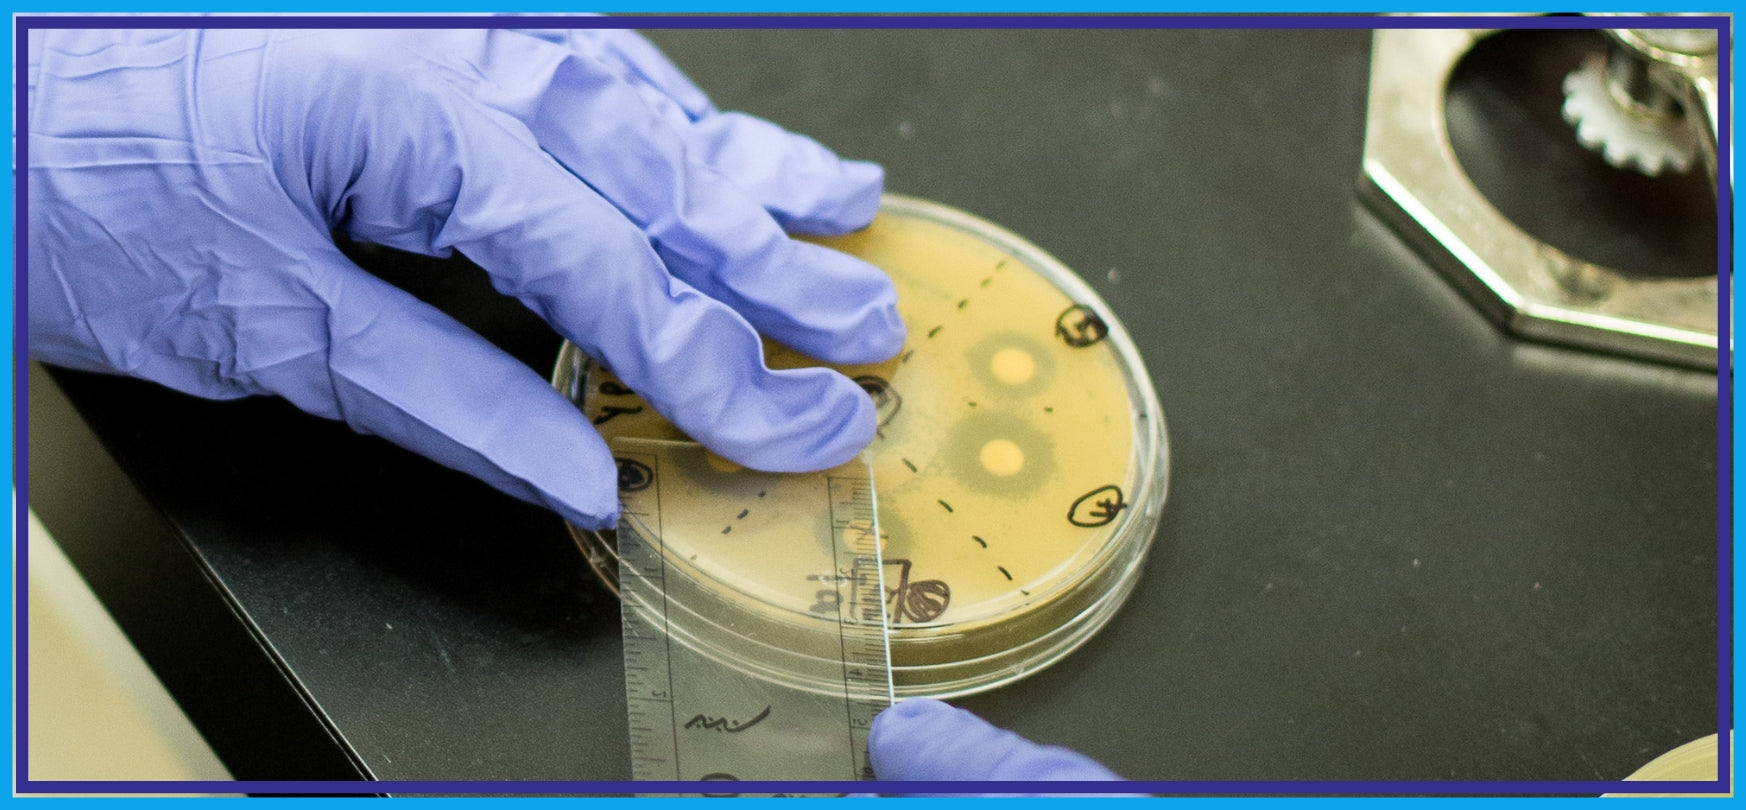
Kirby Bauer antibiotic efficacy test zone of inhibition

Bursting the Bubble, Slaying the `Rat King’
So, you’ve tricked your favorite E. coli expression strain into making gobs of your protein of interest (POI). The SDS-PAGE gel shows a whopping excess...


So, you’ve tricked your favorite E. coli expression strain into making gobs of your protein of interest (POI). The SDS-PAGE gel shows a whopping excess...
Rather than going through the steps addressed in the video, this article will just highlight important things to consider so you’re prepared to test when...

Sir, if you were my husband, I’d put arsenic in your tea.” -Lady Astor to Winston Churchill Being colorless, odorless, tasteless in food and beverages,...

Whether we are conscious of it or not, we will spend our entire life trying to elude death. Despite fruitless attempts to escape, our healthy...

When I was a young research associate, having just recently started down a career of molecular biology and facing the insurmountable task of figuring out...

Our modern day view of our bodies has changed quite drastically over the last century. With increased medical knowledge and the ability to detect ever-smaller...

In part two of our series of blogs highlighting recently published research involving the use of bialaphos and PPT, we now present a summary of...

Lifesaving, man-made “nano-bots,” something long imagined in fiction, are now being brought to life through DNA origami. What started out as a nanoscale 3-D box...

Farmers are constantly in need of a more diversified herbicide treatment program. Though RoundUp has held the position of the world’s top selling herbicide for...

There is, I think, one thing that unifies nearly every species on Earth, a single constant that goes beyond similarities in DNA, genomes, cells or...

It is probably a safe bet that everyone reading this knows at least one person who has diabetes. Diabetes is such a common disease in...

I believe that our current quality of life has been most affected by the discovery of vaccines, even more so than by our use of...
